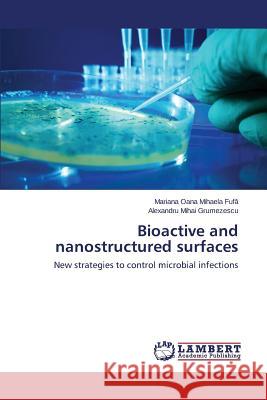
Bioactive and nanostructured surfaces Fufă Mariana Oana Mihaela 9783659327353 LAP Lambert Academic Publishing - książka

Bioactive and nanostructured surfaces » książka
Bioactive and nanostructured surfaces
ISBN-13: 9783659327353 / Angielski / Miękka / 2015 / 108 str.
Since amplified bacterial resistance is becoming a concerning phenomenon, especially due to an increase in the reported complications, specialized medical devices that reduce infection rates are a leading and crucial medical research field. Going forward, the current book addresses one of these possibilities by describing one method of optimizing medical devices by modifying them with nanostructured surfaces that prevent the development of adherent bacterial biofilms. Prepared by Matrix Assisted Pulsed Laser Evaporation technique, thin coatings based on silver nanoparticles with a crystalline sphere-like morphology and an average diameter under 10 nm showed encouraging results, useful in the biomedical field also because of their selective tissue distribution, as shown during in vitro and in vivo tests. These nanostructured layers coating the surface of medical catheters significantly reduce bacteria attachment and biofilms formation, being perfect candidates for the development of novel anti-infectious therapies. The experimental results presented in this book bring forward an original technique which may be used for optimizing wide use exploratory and prosthetic medical devices.